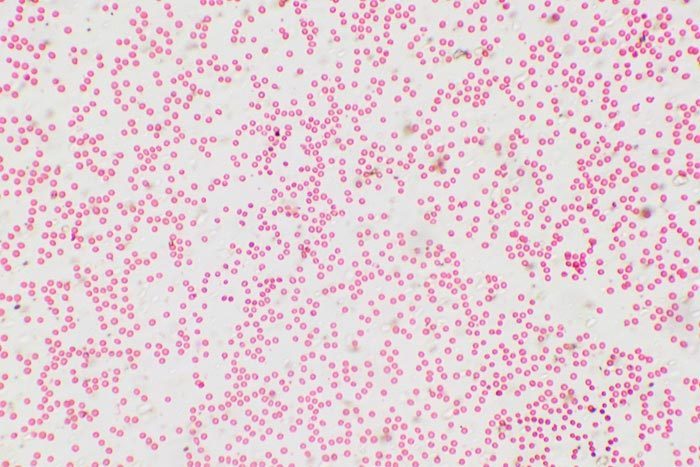

Сравните кровь человека и лягушки. Эритроциты, какой крови переносят больше кислорода и почему?
Приложения:

Ответы
Ответ дал:
0
у человееа больше переносят, т к они безьядерные и значит их больше помкщается в таком же объеме, если брать в сравнении
Вас заинтересует
2 года назад
2 года назад
3 года назад
9 лет назад
9 лет назад